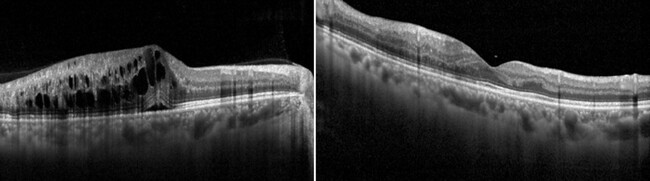

망막혈관폐쇄는 망막에 영양과 산소를 공급하는 혈관이 막혀 시력감소를 초래하는 안질환이다. 건강보험심사평가원에 따르면 망막혈관폐쇄로 진료받은 환자 수는 2013년 4만8953명에서 2023년 8만1430명으로 10년 새 약 66% 증가한 것으로 나타났다.
망막혈관폐쇄는 주로 고혈압과 동맥경화를 비롯한 혈관성 질환에 의해 발생하며 당뇨병과 고지혈증 등도 발병 위험을 높이는 주요 요인으로 지목되고 있다. 특히 전신 혈관 건강에 영향을 미치는 만성질환을 함께 앓고 있다면 발생 가능성이 더욱 증가한다.
망막혈관폐쇄는 별다른 전조증상 없이 갑작스러운 시력저하가 나타나는 경우가 많으며, 환자 상당수가 50대 이상 중·장년층이다. 고혈압·당뇨병·고지혈증 등 만성질환을 앓고 있는 경우 정기적인 안과 검진을 통해 발병 유무를 확인하는 게 중요하다. 최근 젊은 연령층에서도 고혈압 유병률이 증가하고 있는 만큼, 혈압 등 위험요인을 철저하게 관리해 망막혈관폐쇄를 비롯한 다양한 혈관성 합병증을 예방할 필요가 있다.
망막혈관폐쇄는 막힌 혈관 위치에 따라 망막동맥폐쇄와 망막정맥폐쇄로 구분된다. 망막동맥폐쇄는 주로 경동맥이나 심장에서 기원한 색전이나 국소 혈전에 의해 발생하며, 고혈압, 동맥경화성 뇌심혈관질환 등의 전신 혈관 위험인자가 흔히 동반된다. 대개 통증 없이 갑자기 시야 일부 또는 전체가 어두워지거나 심한 시력 저하가 나타나는 응급질환으로, 이런 증상이 발생할 경우 지체 없이 안과진료를 받는 게 중요하다. 환자들이 증상 시점을 정확히 인지하지 못하거나 응급으로 인식하지 않아 내원이 늦어지는 경우가 적잖아 주의가 필요하다.
망막정맥폐쇄는 폐쇄된 정맥의 위치와 범위에 따라 임상 경과와 예후가 크게 달라질 수 있다. 황반 허혈이 동반되지 않은 경우에는 망막출혈과 황반부종이 시간 경과에 따라 자연 흡수되면서 시력 회복을 기대할 수 있다. 그러나 광범위한 출혈이나 허혈성 변화가 발생한 경우에는 적극적인 치료에도 불구하고 시력 회복이 제한적인 경우가 많다. 또 망막정맥폐쇄는 반대쪽 눈에서 발생하거나 양안에 순차적 또는 동시 발병할 가능성이 망막동맥폐쇄에 비해 상대적으로 높은 편이다. 초기 진단 이후에도 장기적인 경과 관찰과 체계적인 관리가 필요하다. 이 경우 조기 진단을 바탕으로 항혈관내피성장인자(anti-VEGF) 주사치료 등 적극적인 치료 전략을 통해 합병증 발생을 최소화하는 게 중요하다.
망막혈관폐쇄가 이미 발병했다면 혈압 및 혈당을 관리하더라도 발병 이전의 상태로 완전한 회복을 기대하기는 어렵다. 다만 전신 상태를 안정적으로 관리하면서 치료를 병행할 경우 망막 출혈 흡수와 황반부종 감소를 통해 시력 저하를 억제하고 증상 개선을 기대할 수 있다. 또 고혈압, 고지혈증, 당뇨병 등 만성질환을 철저히 관리하고, 규칙적인 운동과 금연·절주 등 생활습관을 개선하면 재발 위험을 낮추고 장기적인 시력 보호에 도움이 된다. 망막정맥폐쇄에서 항혈관내피성장인자 항체 주사치료 전(왼쪽), 항혈관내피성장인자 항체 주사치료 후 황반부종이 호전된 소견. 출처 김안과병원
망막정맥폐쇄에서 항혈관내피성장인자 항체 주사치료 전(왼쪽), 항혈관내피성장인자 항체 주사치료 후 황반부종이 호전된 소견. 출처 김안과병원
망막혈관폐쇄는 유리체출혈, 황반부종, 신생혈관 녹내장 등 시력을 위협하는 심각한 합병증으로 진행할 수 있어 조기치료와 지속적인 추적관찰이 필수적이다. 특히 망막동맥폐쇄의 경우 안구 혈관에 발생한 색전이 전신 혈관질환의 신호일 수 있으며, 뇌혈관으로의 색전 동반 위험이 높아 심장 및 뇌혈관에 대한 정밀 검사를 함께 시행하는 게 중요하다. 이에 따라 망막동맥폐쇄 환자에서는 안과적 치료에 국한하지 않고 전신 혈관 상태를 종합적으로 평가해 2차적인 중증 합병증을 예방하는 접근이 요구된다.
김예지 김안과병원 망막병원 전문의는 “고혈압, 당뇨병 등 만성질환이 있다면 생활습관 개선과 전신질환 관리를 통해 눈 건강을 조기에 관리해야 한다”며 “만약 시력이 저하되는 듯한 증상이 나타난다면 안과에 내원해 정확한 진단을 받아볼 것을 권장한다”고 조언했다.

